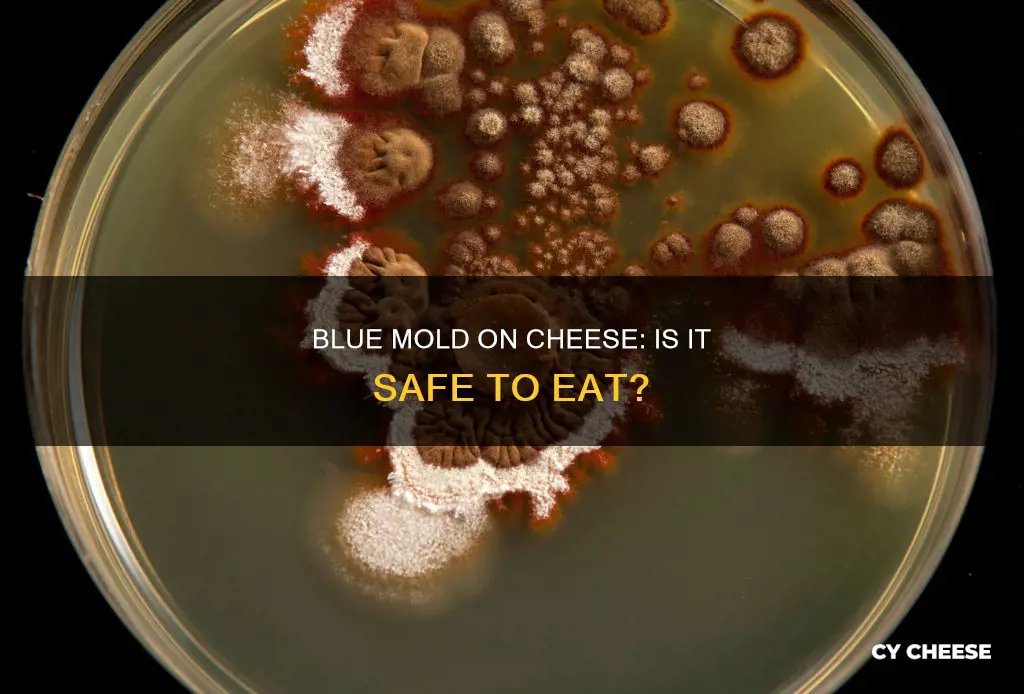
will blue mold on cheese hurt you

Blue cheese is characterized by its bluish veins, which are caused by the growth of mold spores injected into the curds. While the thought of eating mold may be off-putting, the molds used in cheesemaking are generally safe to consume and are even essential for developing the unique flavors and textures of certain varieties of cheese. However, it is important to distinguish between the good and bad molds on cheese.
| Characteristics | Values |
|---|---|
| Is blue mold on cheese harmful? | In most cases, blue mold on cheese is not harmful. However, it is recommended to cut off the moldy part before consuming the cheese. |
| Reasons for mold on cheese | Mold is used in cheesemaking to develop flavor and texture. It is characterized by blue veins inside the cheese or a thick white rind on the outside. |
| Types of mold used in cheesemaking | Penicillium roqueforti, P. glaucum, and P. candidum. |
| Cheese varieties with blue mold | Blue cheese, Brie, Camembert, Humboldt Fog, St. André, and Gorgonzola. |
| Preventing mold on cheese | Store cheese properly, wrap it in special cheese paper or parchment paper, and consume it within a reasonable time frame. |
| Health risks of consuming moldy cheese | In rare cases, mold on cheese can carry harmful bacteria such as E. coli, Listeria, Salmonella, and Brucella, which can cause food poisoning. |
Explore related products
What You'll Learn

Blue mold on cheese is generally safe to eat
It's understandable to be concerned about the safety of consuming blue mold-covered cheese. However, it's important to distinguish between the types of mold that are generally safe to eat and those that are not. Blue mold on cheese is typically safe for consumption and is intentionally introduced during the cheesemaking process to create distinct flavors and textures.
The presence of blue mold on cheese is often intentional and a result of the introduction of specific mold cultures, such as Penicillium roqueforti, during the cheesemaking process. This mold is responsible for the characteristic bluish veins found in blue cheeses like Gorgonzola. Cheesemakers carefully control the growth of this mold to ensure it remains within safe and desirable limits.
While blue mold on cheese is generally safe, it's important to exercise caution and examine the cheese before consumption. If the cheese has been properly stored and handled, and the mold is confined to a small area, it is likely safe to consume the cheese after cutting away a substantial portion around the moldy section. This ensures the removal of any potentially harmful spores that may be present.
However, it is crucial to differentiate between the desirable blue mold and other types of mold that may be unsafe. If the cheese is extensively coated in mold or exhibits signs of spoilage, such as an off-putting odor or discoloration beyond the blue veins, it is best to discard it. Additionally, certain types of cheese, such as fresh soft cheeses like ricotta or cottage cheese, should be discarded at the first sign of any mold due to their high moisture content, which can facilitate the rapid growth of harmful bacteria.
In summary, blue mold on cheese, when confined to a small area and resulting from the controlled introduction during cheesemaking, is generally safe to consume after removing a substantial portion of the surrounding cheese. However, always exercise caution, and if in doubt, discard the cheese to prevent any potential health risks associated with mold consumption.
The Truth About Castello Blue Cheese Pasteurization
You may want to see also

Blue mold is used to make blue cheese and soft-ripened cheeses
Blue mold, or Penicillium roqueforti, is a cousin to the mold that produces penicillin. It is used to make blue cheese and is characterized by blue veins inside the cheese. Blue cheese is made by injecting spores into the curds. The mild flavor of blue mold is chosen intentionally to taste good. This nontoxic mold forms on the cheese to prevent other harmful molds from attacking it.
Soft-ripened cheeses, such as Brie, Camembert, Humboldt Fog, and St. André, are made by mixing mold into the milk during processing. They are characterized by a thick, white rind on the outside, which is also a type of mold called Penicillium candidum. This mold grows naturally on the cheese, and cheesemakers pat it down, flip the cheese, and let the process repeat. The result is a savory, mushroomy white rind that gives soft-ripened cheeses their distinct flavor and texture.
While blue mold and other molds used in cheesemaking are generally safe to consume, it is important to practice proper storage and handling of cheese to prevent spoilage and the growth of harmful molds.
The Delicious Art of Melting Blue Cheese
You may want to see also

Harmful molds can't compete with the edible blue mold
The discovery of mould on cheese can be distressing, especially when it's on something as beloved as cheese. But fear not, because mouldy cheese is not always unsafe to eat. In fact, all cheese is, in and of itself, mould.
The mould that builds up on food is not safe to eat, but the mould on blue cheese is chosen to taste good and is edible. The mould on blue cheese is called Penicillium roqueforti, a cousin of the penicillin-producing Penicillium. This edible mould prevents other harmful moulds from attacking the cheese. While the mould itself may not be harmful, it can carry dangerous bacteria, including E. coli, Listeria, Salmonella, and Brucella, which can cause food poisoning. Therefore, it is important to know how to handle mould on cheese.
Fresh soft cheeses like ricotta, mascarpone, and chèvre should be discarded if mould appears, as the damp environment means that the mould has likely penetrated deep into the cheese and negatively impacted its flavour. However, for soft cheeses like Brie or Port Salut, it is safe to cut away about a quarter of an inch from any surface where mould is visible. Hard cheeses like Parmesan, Colby, Swiss, and Cheddar can also be salvaged by cutting around the moulded area, as it is rare for spores to spread far beyond the surface.
While it may be tempting to try to salvage mouldy cheese, it is important to use your best judgement and err on the side of caution. When in doubt, it is always better to discard the cheese than risk potential foodborne illnesses.
Blue Cheese and FODMAP: What's the Lowdown?
You may want to see also
Explore related products

Blue mold on cheese is rarely a health concern
It is rare for blue mold on cheese to be a health concern. In fact, blue mold is often deliberately introduced during the cheesemaking process to develop flavor and texture. These kinds of mold are perfectly safe to consume and are characterized by blue veins inside the cheese.
Blue mold on cheese is typically safe to consume, but it's important to distinguish between the types of mold. The molds used in cheesemaking, such as Penicillium roqueforti, P. glaucum, and P. candidum, are safe to eat and give cheese its distinct flavor and texture. On the other hand, mold that grows on old cheese is usually unsafe and can be harmful.
While blue mold on cheese is generally safe, it's important to practice caution. Some people might be allergic to certain types of mold, even if they are used in cheesemaking. Additionally, mold can carry harmful bacteria, such as E. coli, Listeria, Salmonella, and Brucella, which can cause food poisoning. Therefore, it's always a good idea to assess the mold situation and cut away any affected areas before consuming the cheese.
Furthermore, fresh soft cheeses, such as ricotta, mascarpone, and chèvre, should be discarded if mold appears, as the damp environment allows mold to penetrate deep into the cheese and negatively impact its flavor. Hard cheeses, on the other hand, can usually be salvaged by cutting away the molded portion, as it is rare for spores to spread beyond the surface.
The Ancient Origins of Blue Cheese
You may want to see also

Blue mold on hard cheeses can be cut off and the rest of the cheese consumed
It is generally safe to cut off the moldy parts of hard cheeses, such as Parmesan, Colby, Swiss, and Cheddar, and consume the rest of the cheese. This is because it is rare for mold spores to spread beyond the surface of hard cheeses. However, it is important to note that mold can carry harmful bacteria, including E. coli, Listeria, Salmonella, and Brucella, which can cause food poisoning. Therefore, it is always a good idea to assess the mold situation first and cut off at least a quarter of an inch around any surface where mold is visible.
Molds are a type of fungus that produces spores, which are transported through air, insects, and water. They can be found everywhere in the environment, including your refrigerator, but they grow best in warm, moist conditions. While mold is a sign of spoilage in most foods, certain types of mold are used in cheesemaking to develop flavor and texture. These kinds of mold are perfectly safe to consume.
The most common types of mold used to grow cheese are Penicillium (P.) roqueforti, P. glaucum, and P. candidum. These molds help develop unique flavors and textures by eating the proteins and sugars in the milk, resulting in chemical changes. For example, mold is what creates the distinct bluish veins in blue cheese and the thick outer rind and soft, creamy interior of Brie.
While blue mold on hard cheese can be cut off and the rest of the cheese consumed, it is important to be cautious with soft cheeses. Soft cheeses, such as cream cheese, cottage cheese, and ricotta, should be thrown out if mold appears, as the spores can easily contaminate the entire product. For soft cheeses like Brie or Port Salut, it is recommended to cut off at least a quarter of an inch around any surface where mold is visible.
Blue Cheese Bechamel: A Decadent Twist on a Classic
You may want to see also
Frequently asked questions
Blue mold on cheese is generally not dangerous. Blue cheese is made with mold, which is what creates its distinct bluish veins. The mold used in cheesemaking is safe to eat and is characterized by blue veins inside the cheese.
The mold used in cheesemaking is different from the mold that sprouts on old cheese and bread. The former is safe to eat and is characterized by blue veins inside the cheese or a thick, white rind on the outside. The latter is typically a fuzzy growth that varies in color from white to green.
If you see mold on your cheese, you don't necessarily have to throw it out. It's rare for spores to spread far beyond the surface of hard cheeses, such as Parmesan, Colby, Swiss, and Cheddar. You can cut off the moldy part and eat the rest of the cheese. However, if the cheese is soft, the mold has likely penetrated deep into the cheese, so it's best to discard it.

























